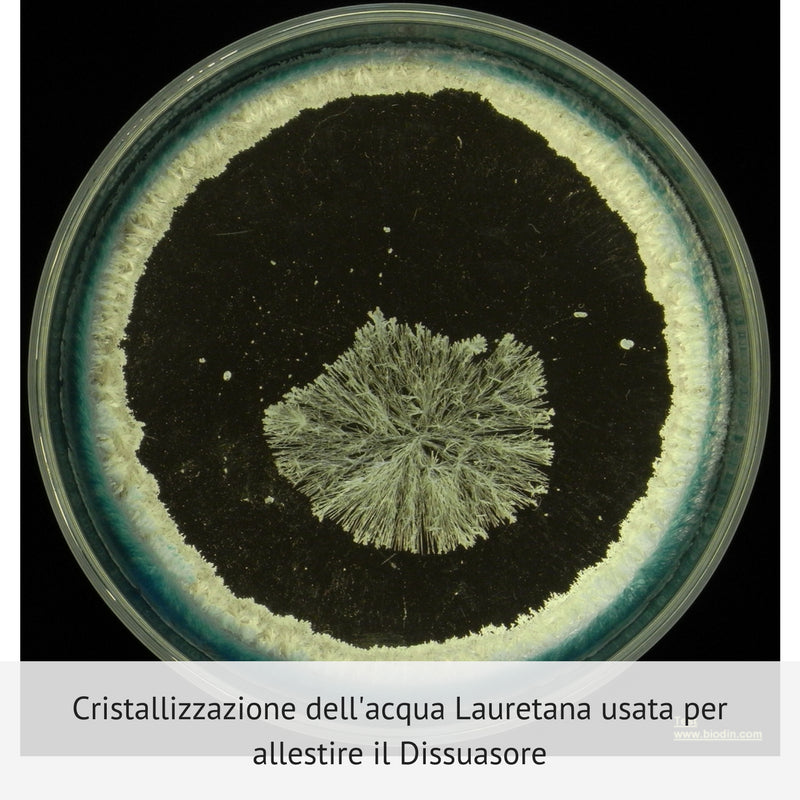

Dissuasore BioDinamico per il Cinghiale - 1 lt
Have a question?




Dissuasore BioDinamico per il Cinghiale - 1 lt
Dettagli
SCHEDA D’USO DEL DISSUASORE BIODINAMICO PER IL CINGHIALE
I dissuasori biodinamici sono dei prodotti omeopatici biodinamici che non hanno assolutamente nessun altro effetto collaterale su altri insetti, animali, piante od esseri umani anche nel caso di contatto od addirittura di ingestione diretta. I dissuasori bd hanno una azione repellente, ovvero creano le condizioni per allontanare l’animale o insetto indesiderato, per almeno 60 giorni a partire dal terzo giorno dopo che è stato dinamizzato ed irrorato, a condizione di osservare in maniera precisa le indicazioni di uso sottoriportate.
1) Oltre al seguire in modo preciso le indicazioni d’uso compresa la corretta dinamizzazione, altri elementi che possano inficiare o ridurre il funzionamento del prodotto sono: un livello di humus basso nel terreno (sotto l’1%), uso di concimi chimici, pesticidi e veleni vari nello stesso campo agricolo, lavorazioni del terreno e compattamento del terreno
2) Il Dissuasore Biodinamico per il cinghiale viene allestito usando processi di dinamizzazione e di omeopatizzazione usando lo stesso insetto che causa il danno attraverso una serie ritmica di dinamizzazioni biodinamiche e potentizzazioni omeopatiche
3) Questo dissuasore bd, che prima di essere usato deve venire dinamizzato per un’ora, crea un campo vibrazionale negativo che allontana dalla zona dove è irrorato l’insetto indesiderato
4) Se vi è un clima troppo secco questo fatto ne può depotenziare l’azione, in questo caso usare il dissuasore il più tardi possibile la sera in modo da avere un minimo di umidità, oppure nei mesi più caldi richiedere la formulazione del dissuasore CH
5) La pioggia, umidità, neve, gelo od altri “eccessi” di acqua invece non solo non ne danneggiano l’azione ma la potenziano
6) Sull’etichetta è scritta la data di allestimento del dissuasore bd e lo stesso prodotto è valido e funzionante per 3 anni a partire dalla stessa data
7) Dare qualche succussione alla bottiglia e dinamizzare il litro (o parte) del dissuasore di cinghiale con al max 80 -100 litri di acqua a 37 – 38° di fonte, di pozzo, assolutamente non clorata e con Ph inf. a 6,5 – 7
8) Se avete acqua con pH elevato o clorata potete usare il filtro per acqua Doulton
9) dinamizzare per un’ora (come un preparato biodinamico) 1 litro del dissuasore con 50 -80 litri di acqua e spruzzare il liquido con un atomizzatore a goccia finissima sulla pianta, nell’aria e sul terreno dove si può annidare.
10) Se la superficie da irrorare è più piccola usare solo una parte di essa: per esempio per 1000 m2 servono 100 cc di dissuasore bd
11) Se non sapete cosa sia la dinamizzazione leggetevi la scheda sulla dinamizzazione biodinamica sul sito ww.agribionotizie.it
12) Eseguire l’operazione di dinamizzazione e spruzzatura nel pomeriggio/sera con la presenza di umidità
13) Il liquido agisce pienamente dal terzo giorno dopo la spruzzatura per circa 60 giorni
14) La prima volta ripetere l’operazione dopo 2 - 4 giorni x almeno 3 volte usando anche lo stesso liquido già dinamizzato (se dinamizzato a mano)
15) La copertura del dissuasore verificata è di 60 giorni (ho avuto casi di 90 giorni di copertura totale senza la presenza del parassita)
16) Usare sempre una pompa od uno spruzzino perfettamente puliti (senza residui di altri trattamenti)
17) Per pulire gli spruzzini od atomizzatori usate soda caustica
18) L’azione del preparato funziona molto bene come preventivo
19) Spruzzare bene in alto sulla chioma della pianta il dissuasore in modo che avvolga come una nuvola la pianta e/o sul terreno dove l’animale fa danni
20) Per una completa azione si consiglia di usare il Dissuasore BD:
• nei giorni centrali del periodo astronomico del Sole in Capricorno
• con Luna in Capricorno
• Nella settimana dopo Pasqua
• Nel pomeriggio/sera con umidità nell’aria e nel terreno
• Con Luna Discendente
• Con umidità nell’aria e nel terreno
Precauzioni
a) Tenere lontano mentre dinamizzate cellulari ed apparecchi elettrici
b) Per diluire usare acqua di fonte con Ph inferiore a 7
c) Per controllare il Ph dell’acqua della vostra zona usare le cartine tornasole
d) Per piccole dosi usate acqua minerale consiglio l’Acqua Lauretana che ha un Ph 6 o acqua distillata
e) L’acqua di dinamizzazione deve essere a temperatura di 37 – 39°
f) Tenere i dissuasori bd fino a che non le usate in un armadietto chiuso al buio lontano da prese elettriche o fonti elettromagnetiche